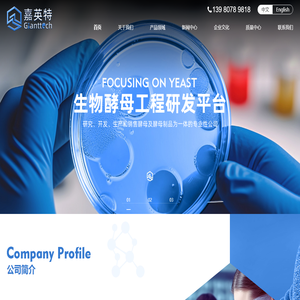
四川嘉英特生物科技有限公司

四川嘉英特生物科技有限公司
四川嘉英特生物科技有限公司
SEO更新时间
2026-04-16T07:32:08
 0
0百度移动:
 0
0360 权重:
 0
0搜狗权重:
 0
0
网站标签四川嘉英特生物科技有限公司、 酵母制品生产厂家、 四川生物公司、 牛骨蛋白胨、 酵母粉、 微美酵母粉、
网站描述四川嘉英特生物科技有限公司是一家集研究、开发、生产和销售酵母及酵母制品为一体的专业性公司。公司主要产品有:糖蜜酵母、微美酵母粉、酵母粉(抗生素发酵培养基)、复合酵母粉、复合氨基酸粉、酵母抽提物、酵母浸膏、酵母自溶粉、蛋白胨、菲丁、玉米浆、丝素粉等,我公司是生物医药行业中重要的生化药用原料生产厂家,并与国内几所高等院校建立长期合作关系,其产品质量严格按照相关的国家标准执行,深受用户的好评和信赖。
上一篇:华域生物科技发展(天津)有限公司
下一篇:德阳林奇百货有限公司
网站快照四 川 嘉 英 特 生 物 科 技 有 限 公 司 酵 母 制 品 生 产 厂 家 中 文 E n g l i s h 1 3 9 8 0 7 8 9 8 1 8 首 页 关 于 我 们 产 品 领 域 新 闻 中 心 企 业 文 化 质 量 中 心 联 系 我 们 0 1 0 2 0 3 公 司 简 介 2 0 2 3 公 司 成 立 于 ( 年 ) 2 0 + 研 发 产 品 ( 个 ) 1 0 0 + 服 务 客 户 ( 个 ) 5 0 + 企 业 团 队 ( 人 ) 四 川 嘉 英 特 生 物 科 技 有 限 公 司 四 川 嘉 英 特 生 物 科 技 有 限 公 司 是 一 家 集 研 究 、 开 发 、 生 产 和 销 售 酵 母 及 酵 母 制 品 为 一 体 的 专 业 性 公 司 。 公 司 主 要 产 品 有 : 糖 蜜 酵 母 、 微 美 酵 母 粉 、 酵 母 粉 ( 抗 生 素 发 酵 培 养 基 ) 、 复 合 酵 母 粉 、 复 合 氨 基 酸 粉 、 酵 母 抽 提 物 、 酵 母 浸 膏 、 酵 母 自 溶 粉 、 蛋 白 胨 、 菲 丁 、 玉 米 浆 、 丝 素 粉 等 , 我 公 司 是 生 物 医 药 行 业 中 重 要 的 生 化 药 用 原 料 生 产 厂 家 , 并 与 国 内 几 所 高 等 院 校 建 立 长 期 合 作 关 系 , 其 产 品 质 量 严 格 按 照 相 关 的 国 家 标 准 执 行 , 深 受 用 户 的 好 评 和 信 赖 。 公 司 优 价 提 供 多 种 兽 药 农 药 产 品 : 阿 维 菌 素 、 伊 维 菌 素 、 甲 维 盐 、 盐 霉 素 、 红 霉 素 、 马 杜 霉 素 、 金 霉 素 、 硫 酸 粘 杆 菌 素 、 肌 醇 、 截 短 侧 耳 素 等 , 品 种 丰 富 , 质 量 上 乘 。 本 公 司 遵 循 “ 以 科 技 求 发 展 , 以 质 量 求 效 益 ” 的 宗 旨 , 建 立 了 科 学 的 生 产 管 理 和 完 善 的 质 量 保 证 体 系 , 使 公 司 规 模 不 断 扩 大 , 产 品 畅 销 海 内 外 。 多 年 的 经 验 积 累 、 产 品 的 不 断 创 新 、 服 务 的 诚 信 优 质 得 到 了 客 户 的 一 致 肯 定 和 好 评 , 为 企 业 赢 得 了 卓 越 商 誉 。 我 公 司 拥 有 科 研 、 生 产 设 备 和 完 善 的 研 发 、 检 测 系 统 , 致 力 于 生 物 发 酵 工 程 领 域 的 研 究 、 开 发 和 生 产 , 以 期 为 国 内 、 国 际 生 物 工 程 领 域 做 出 更 大 的 贡 献 。 M o r e → 产 品 领 域 微 生 物 营 养 微 美 酵 母 粉 、 酵 母 抽 提 物 、 酵 母 浸 膏 、 玉 米 浆 植 物 营 养 糖 蜜 酵 母 、 酵 母 粉 ( 抗 生 素 发 酵 培 养 基 ) 、 菲 丁 培 养 基 ) 动 物 营 养 复 合 酵 母 粉 、 复 合 氨 基 酸 粉 、 酵 母 自 溶 粉 、 蛋 白 胨 工 业 用 途 玉 米 浆 、 丝 素 粉 玉 米 浆 企 业 优 势 创 新 技 术 不 断 创 新 新 技 术 并 与 国 内 几 所 高 等 院 校 建 立 长 期 合 作 关 系 产 品 丰 富 产 品 多 元 化 , 涵 盖 多 个 行 业 和 领 域 , 满 足 更 多 客 户 需 求 严 苛 质 检 产 品 质 量 严 格 按 照 相 关 的 国 家 标 准 执 行 , 质 量 上 乘 设 备 过 硬 公 司 有 专 业 的 科 研 团 队 、 完 善 的 生 产 设 备 和 研 发 检 测 系 统 M o r e → 新 闻 中 心 酵 母 抽 提 物 在 食 品 工 业 中 的 应 用 酵 母 抽 提 物 由 于 其 独 特 的 调 味 特 性 和 优 良 的 营 养 保 健 特 性 , 在 天 然 调 味 料 领 域 中 正 逐 步 取 代 其 它 调 味 料 而 占 主 导 地 位 , 应 用 范 围 非 常 广 泛 。 2 0 2 3 1 2 2 1 酒 酵 母 粉 是 什 么 啤 酒 酵 母 粉 初 期 是 利 用 啤 酒 花 ( 酿 制 啤 酒 的 原 料 之 一 ) 培 养 的 , 一 般 称 为 营 养 酵 母 。 由 于 含 有 大 量 矿 物 质 , 因 此 苦 味 较 重 、 颜 色 较 黑 , 因 此 亦 称 为 黑 啤 酒 酵 母 粉 。 后 来 随 著 食 品 工 业 的 进 步 , 发 展 2 0 2 3 1 2 2 1 酵 母 抽 提 物 发 展 前 景 2 0 2 3 1 2 2 1 酵 母 粉 市 场 2 0 2 3 1 2 2 1 M o r e → 联 系 方 式 电 话 : 1 3 9 8 0 7 8 9 8 1 8 地 址 : 成 都 市 锦 江 区 驿 都 西 路 3 1 6 号 绿 地 中 心 4 6 8 锦 峰 2 6 0 7 号 手 机 版 小 程 序 网 站 导 航 关 于 我 们 产 品 领 域 新 闻 中 心 企 业 文 化 质 量 中 心 联 系 我 们 C o p y r i g h t 2 0 2 3 2 0 2 4 四 川 嘉 英 特 生 物 科 技 有 限 公 司 A l l r i g h t s r e s e r v e d 备 案 号 : 蜀 I C P 备 2 0 2 3 0 4 1 4 9 9 号 网 站 建 设 : 互 成 网 络
网站说明:www.jiayingte.com由网友主动性提交被名站导航整理收录的,名站导航仅提供网站的基础信息并免费向大众网友展示,www.jiayingte.com的IP地址:- 地址:-,百度PC权重为0、百度手机权重为0、百度收录为0条、360收录为0条、搜狗收录为0条、谷歌收录为0条、百度来访流量大约在-之间、百度手机端来访流量大约在-之间、www.jiayingte.com的备案号是-、备案主体是-、被百度收录的关键词有0个、手机端关键词有0个、该站点迄今为止已经创建未知。
内容声明:1、本站收录的内容来源于大数据收集,版权归原网站所有!
2、本站收录的内容若侵害到您的利益,请联系我们进行删除处理!
3、本站不接受违规信息,如您发现违规内容,请联系我们进行清除处理!
4、本文地址:https://www.hornyrob.com/bianchengdh/4f55e4ec8e29cfef503a.html,复制请保留版权链接!